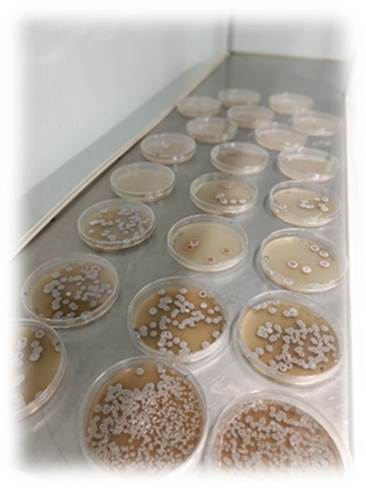

Microbiology helps turn living microbes into medicines. By growing bacteria, yeast, or fungus under strict conditions, companies can produce vaccines, proteins (like insulin or antibodies), and antibiotics. Because patients rely on these medicines, every step is carefully controlled, tested, and documented to meet regulatory standards (GMP). The main goal is safety, purity, and consistent performance from batch to batch.
How a fermentation-based API is made
- Master Cell Bank (MCB) and Working Cell Bank (WCB)
- MCB: A frozen, highly stable stock of a single microbial clone. It protects genetic stability.
- WCB: Derived from the MCB and used for routine production.
- Storage: Very cold (≤ -70°C or in liquid nitrogen) to keep the organism unchanged.
- Why it matters: Keeps the starting microorganism consistent, which is crucial for product quality.

- Inoculum Development
- Start with a small amount from the WCB and grow it in small vessels (shake flasks or seed bioreactors).
- Gradually scale up to the amount needed for the main production run.
- Key controls: pH, temperature, oxygen (dissolved oxygen, DO), and nutrients.
- Why it matters: Produces a healthy, uniform population ready for large-scale growth.



- Large-Scale Fermentation
- Conducted in sterile steel bioreactors, ranging from hundreds to thousands of liters.
- Key controls:
- Aeration and agitation: Ensures enough oxygen for growth.
- Nutrient feed strategy: Fed-batch or continuous feeding to maximize yield.
- pH and temperature: Kept within narrow ranges suitable for the organism.
- Foam control: Antifoam agents prevent overflow.
- Outcome: Microbes grow and produce the desired API or its precursors.


- Harvest and Primary Recovery
- Separation: Centrifugation or microfiltration removes most of the microbial cells from the broth.
- How impurities are handled depends on the API:
- Intracellular APIs: Break open the cells (lysis) and purify the product.
- Extracellular APIs: Directly purify from the liquid.
- Purification
- Main tools: Chromatography (to remove impurities), and ultrafiltration/diafiltration (to concentrate and exchange buffers).
- For solids: Crystallization is used.
- For liquids: Sterile filtration (0.22 μm) to ensure sterility before final filling.
- Why it matters: Removes impurities, concentrates the product, and prepares it for formulation.
Quality and microbiological controls
1. Contamination prevention during production
- Use closed systems and sterile gas to limit exposure to outside microbes.
- Media sterilization: heat (SIP – Steam-In-Place) or filtration.
- Bioburden monitoring: regular checks of the broth for unwanted microbes.
- Endotoxin control: crucial for injectable products.
2. Microbiological checks in the final API
- Final product must meet pharmacopeial standards (USP, EP, JP).
- Bioburden testing (Total Viable Count, TVC) is done before terminal sterilization.
- Sterility testing is required for sterile APIs.
- Endotoxin testing is required for parenteral products.
Environmental Monitoring in GMP facilities
Rigorous monitoring reduces contamination risk in the manufacturing environment.
- Equipment and Surfaces
- Regular swab or rinse testing to detect biofilm-forming microbes (e.g., Pseudomonas).
- CIP/SIP validation ensures cleaning and sterilization are effective.
- Cleanrooms and HVAC Systems
- Air monitoring: active air sampling (impaction) and settle plates (passive).
- Non-viable particle counts align with ISO 14644-1 standards (e.g., ISO 5 for aseptic areas).
- Pressure cascades help prevent cross-contamination between zones.
- Purified Water Systems
- Water quality guidelines (USP <1231>):
- Purified Water (PW):< 100 CFU/mL (microbial limits).
- Water for Injection (WFI): Must be sterile and endotoxin-free.
- Biofilm control: regular sanitization (e.g., ozone, hot water >80°C, UV).
Final thoughts: Why this all matters
Fermentation-based API production is a highly controlled, GMP-driven process. Microbiological oversight – from the initial cell banks to environmental monitoring and water quality – ensures APIs are safe, effective, and consistently produced. The combination of careful planning, robust testing, and strict cleaning and monitoring helps protect patients and uphold regulatory standards.
Marina Guerra
Applied Microbiology Lab Manager at Suanfarma CDMO Cipan